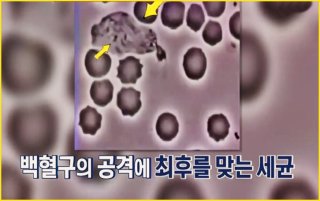

백혈구 수치가 높으면 나타나는 증상 10가지 깊이 있는 가이드
병원에서 혈액검사를 하면 혈당, 콜레스테롤과 함께 늘 체크되는 것이 바로 백혈구 수치다. 백혈구는 우리 몸에서 감염과 싸우는 가장 중요한 방어군으로, 세균이나 바이러스가 몸에 들어오면 곧장 늘어나 이들을 제거한다. 그런데 백혈구 수치가 높으면 무조건 좋은 걸까?
사실은 전혀 그렇지 않다. 백혈구 수치는 정상범위보다 높으면 우리 몸 어딘가에 염증이나 감염이 있음을 알리는 신호일 가능성이 크다. 또는 만성 질환이나 특정 혈액질환의 징후일 수도 있다. 이번 글에서는 백혈구 수치가 높으면 구체적으로 어떤 증상들이 나타나는지, 몸에서 보내는 이상신호 10가지를 하나씩 매우 꼼꼼히 살펴본다.
왜 백혈구 수치가 높으면 문제가 될까?
보통 건강검진 결과에서 백혈구(WBC)는 4,000~10,000/μL 정도가 정상으로 본다. 그런데 백혈구 수치가 높으면 대체로 몸 어딘가에 염증이 있거나, 감염과 싸우고 있거나, 과도한 스트레스 혹은 흡연·비만 등으로 인해 백혈구가 증가했을 가능성이 크다.
드물게는 백혈병 같은 혈액암의 초기 신호일 수도 있다. 그래서 백혈구 수치가 높으면 그냥 넘기기보다 왜 높아졌는지 원인을 찾는 게 무엇보다 중요하다. 또한 증상이 하나씩 몸에 나타나기 시작할 때는 이미 어느 정도 면역반응 혹은 다른 병적 변화가 진행되고 있을 확률이 높다.
피로감과 무기력
가장 흔히 겪는 증상이 바로 피로다. 백혈구 수치가 높으면 보통 몸 어딘가에서 염증 반응이 진행 중일 때가 많다. 염증이 생기면 우리 몸은 싸우기 위해 에너지를 집중적으로 사용하게 된다. 그러다 보니 일상적인 활동만 해도 금세 지치고, 몸이 무겁게 느껴진다.
단순히 잠을 못 자서 피곤한 게 아니라, 낮에도 눈이 무겁고 의욕이 떨어지는 날이 지속된다면 이는 백혈구가 과도하게 활동하고 있다는 하나의 신호일 수 있다. 백혈구가 높아진 만큼 몸에서 끊임없이 싸우고 있다는 뜻이니 주의가 필요하다.
미열과 몸살 기운
백혈구 수치가 높으면 몸에 감염이 있거나 염증이 퍼지고 있는 경우가 많다. 이때 몸은 체온을 조금 높여 세균이나 바이러스가 활동하기 어렵도록 만든다. 그래서 특별히 감기 기운이 없는데도 체온이 37.5도 정도로 미묘하게 올라간 상태가 이어질 수 있다.
또 몸살처럼 온몸이 쑤시고 관절이 묵직하게 아픈 느낌을 받는다. 평소 같으면 그냥 지나쳤을 통증이 괜히 예민하게 느껴지는 것도 이런 염증 반응 때문이다. 그래서 백혈구 수치가 높으면 괜히 몸이 으슬으슬하거나, 약한 오한까지 동반되는 경우가 있다.
잦은 두통
백혈구가 높아진 상태에서는 혈액의 점도 자체가 약간 증가한다. 그러다 보면 뇌로 가는 혈류가 조금이라도 원활하지 않으면 두통이 더 쉽게 생긴다. 특히 백혈구 수치가 높으면 우리 몸이 끊임없이 싸우고 있는 상태이기 때문에 대사 부산물이 많이 나와 두통을 유발하기도 한다.
머리가 띵하고 무겁거나 조이는 듯한 느낌, 혹은 집중력이 떨어져 멍한 증상이 자주 반복된다면 가볍게 넘기지 말고 한 번쯤 백혈구 수치를 다시 확인해볼 필요가 있다.
입안이 잘 헐고 구내염
면역세포인 백혈구가 과도하게 움직이는 상황은 우리 몸에 과도한 면역반응을 촉발하기도 한다. 그래서 백혈구 수치가 높으면 입안 점막이 약해져 사소한 자극에도 쉽게 헐거나 구내염이 생긴다.
평소보다 혓바늘이 자주 돋거나, 볼 안쪽이 잘 헐어 음식을 먹을 때 따끔거린다면 몸에 경미하더라도 염증이 계속 생기고 있는 상태일 가능성이 크다. 특히 잇몸도 약해져 양치질할 때 피가 나는 빈도도 증가할 수 있다.
목과 겨드랑이, 사타구니 림프절이 붓거나 뻣뻣함
림프절은 백혈구가 모여 적들과 싸우는 전진기지 같은 곳이다. 백혈구 수치가 높으면 림프절에서 활발히 병원체와 싸우느라 부피가 커질 수 있다. 그래서 목 양옆이나 귀 아래, 혹은 겨드랑이, 사타구니를 손으로 만졌을 때 평소보다 뻣뻣하거나 작은 콩알처럼 만져질 수 있다.
림프절이 아프기까지 하면 이미 염증 반응이 한창이라는 뜻이다. 이는 대표적인 면역 반응 신호로, 백혈구 수치가 높으면 몸 어딘가에서 면역세포가 집중적으로 싸우고 있다는 것을 보여준다.
잦은 복통과 소화불량
위장도는 면역세포가 많이 분포한 기관 중 하나다. 그래서 백혈구 수치가 높으면 위장관 점막도 예민해져서 평소보다 복부 팽만감, 소화불량, 가벼운 복통이 자주 동반된다.
특히 헬리코박터균 같은 세균감염이 있거나, 만성 위염 상태에서는 백혈구가 지속적으로 증가하면서 위장 문제를 더 자주 일으킨다. 식후에 배가 쉽게 불러오고 가스가 차거나 더부룩함을 자주 느낀다면 백혈구 수치도 의심해볼 만하다.
숨이 차고 가슴이 두근거림
혈액 내 백혈구가 많으면 자연스럽게 혈액 점도가 높아져 순환이 원활하지 못할 수 있다. 그 결과 산소 전달이 조금만 늦어져도 심장은 이를 보상하기 위해 더 빠르게 뛴다. 그래서 백혈구 수치가 높으면 별일 없이 가만히 있을 때도 괜히 가슴이 두근거리고, 조금만 걸어도 숨이 찬 느낌을 받을 수 있다.
이런 상태가 지속되면 결국 심혈관계에 부담이 커진다. 실제로 급성 감염이나 만성 염증질환에서 심장이 무리를 해서 부정맥까지 동반되는 경우도 있다.
피부 트러블과 가려움
면역세포가 과도하게 활성화되면 피부까지 영향을 미친다. 그래서 백혈구 수치가 높으면 얼굴에 좁쌀 같은 트러블이나 붉은 여드름이 갑자기 많이 올라오기도 한다. 또한 피부가 이유 없이 간지럽고, 특히 밤에 더 심해지는 경우도 있다.
이것은 피부를 지키는 방어벽이 약해진 상태에서 백혈구가 과민반응을 일으켜 생기는 현상이다. 심하면 두드러기처럼 붉게 부풀어 오르기도 한다. 이런 증상은 흔히 스트레스 때문이라 넘기기 쉽지만, 사실 백혈구와 연관된 경우가 많다.
체중 변화
백혈구 수치가 높으면 몸에서 에너지를 비정상적으로 많이 쓰게 된다. 염증과 싸우기 위해 평소보다 더 많은 에너지를 필요로 하기 때문에 식욕이 떨어지고, 조금만 먹어도 살이 빠질 수 있다.
반대로 만성 염증과 스트레스로 인해 식욕이 과도하게 올라가는 경우도 있다. 염증을 억제하기 위해 코르티솔 같은 호르몬이 분비되면서 허기 신호를 잘못 보내기 때문이다. 그래서 이유 없는 체중 감소나 급격한 증가 모두 백혈구 수치가 높을 때 나타나는 몸의 반응일 수 있다.
불안과 불면
백혈구가 지나치게 증가하면 몸 안에서 염증 매개물질(사이토카인)이 많이 분비된다. 이 물질은 뇌까지 영향을 줘 불안감을 유발하거나 수면의 질을 떨어뜨린다. 그래서 백혈구 수치가 높으면 밤에 잠이 잘 안 오고, 자주 깨거나, 자고 일어나도 개운하지 않은 불면증상을 겪기 쉽다.
또 낮 동안 이유 없이 신경이 날카로워지고, 사소한 일에도 불안하거나 예민해지기도 한다. 이는 단순한 기분 문제가 아니라 몸 속 염증 반응이 뇌에 영향을 주고 있다는 신호다.
백혈구 수치가 높으면 나타나는 증상 한눈에 보기
- 쉽게 지치고 온몸이 무거운 만성 피로
- 특별한 이유 없는 미열, 몸살 기운
- 머리가 띵하고 욱신거리는 두통, 집중력 저하
- 구내염, 잇몸 출혈 같은 잦은 입안 문제
- 목, 겨드랑이, 사타구니 림프절이 붓거나 뻣뻣
- 식사 후 더부룩함, 소화불량, 가벼운 복통
- 숨이 차고 가슴이 두근거림
- 여드름과 피부 가려움, 두드러기
- 체중이 급격히 줄거나 오히려 늘어남
- 잠을 설치고 불안감이 커짐
백혈구 수치가 높으면 어떤 검사를 더 받아야 할까?
백혈구 수치가 높으면 단순히 '몸살 기운인가 보다' 하고 넘기기 쉽다. 하지만 수치가 일정 기준(보통 12,000 이상)으로 계속 높다면 추가 검사가 필요하다.
- CRP, ESR(염증반응검사) : 몸에 염증 정도를 가늠
- 혈액도말검사 : 백혈구 형태를 현미경으로 직접 확인
- 혈액종양 관련 검사 : 백혈병 등 혈액질환 감별
- 간기능, 신장기능 검사 : 간, 신장성 염증 확인
- 흉부X선, 복부초음파 : 숨어있는 감염 확인
특히 열이 오래가거나 림프절이 계속 커지는 경우, 설명되지 않는 체중 감소가 동반된다면 반드시 전문의 진료가 필요하다.
백혈구 수치가 높으면 어떻게 관리해야 할까?
- 염증을 키우는 흡연, 음주는 반드시 줄이거나 중단하기
- 가공식품과 당류, 포화지방을 줄이고 항염증 식단 유지
- 수분을 충분히 섭취해 혈액 순환 원활히
- 과격한 운동보다는 가볍게 땀을 내는 산책, 스트레칭이 좋다
- 충분한 수면과 휴식으로 면역 밸런스를 되찾기
마무리
백혈구는 우리 몸을 지키는 든든한 군대 같은 존재다. 하지만 백혈구 수치가 높으면 단순히 “면역이 좋은 상태”가 아니라, 몸 어딘가에서 싸움이 벌어지고 있다는 증거다. 그 싸움이 세균, 바이러스, 만성 염증, 혹은 더 심각한 문제 때문인지를 빨리 알아채는 것이 건강을 지키는 첫걸음이다.
이번에 살펴본 백혈구 수치가 높으면 나타날 수 있는 다양한 증상을 잘 기억해 두자. 조금이라도 몸이 보내는 신호가 보인다면 가볍게 넘기지 말고 병원을 찾아 필요한 검사를 받고, 생활습관도 점검해 보자. 그렇게 하면 훗날 큰 병으로 이어지기 전에 충분히 예방할 수 있다. 우리 몸은 늘 작은 증상으로 먼저 경고를 보낸다. 그 경고를 놓치지 않는 것이야말로 가장 현명한 건강 관리다.